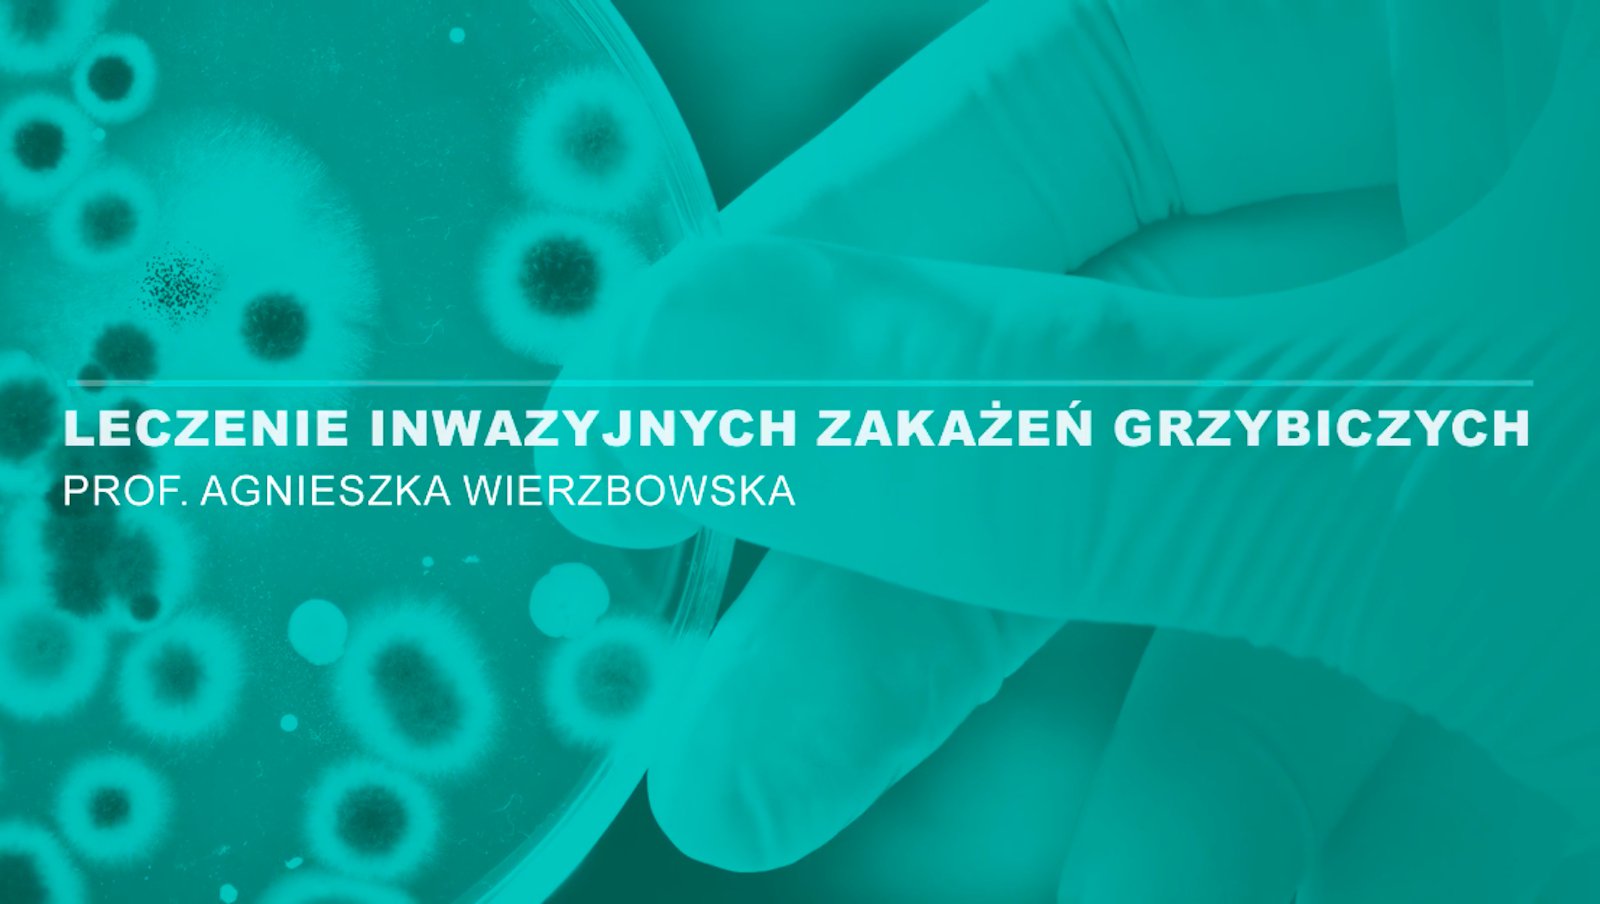
Leczenie inwazyjnych zakażeń grzybiczych | Prof. Agnieszka Wierzbowska

Leczenie wspomagające

18.11.2025
Mira Zyśko
Odczarować fentanyl

14.06.2024
lek. Marta Masternak
Długoterminowa obserwacja potwierdza skuteczność szczepionki przeciwko półpaścowi

6.05.2024
dr n. med. Aleksandra Gołos
Biegunka u chorych z chorobą nowotworową – wytyczne Europejskiego Towarzystwa Onkologii (ESMO)

12.04.2024
Hematoonkologia.pl
Dr Marta Morawska o profilaktyce pierwotnej i wtórnej gorączki neutropenicznej
![Prof. Krzysztof Giannopoulos: Co nowego w obszarze G-CSF? [VIDEO]](/uploads/artykuly/co-nowego-gcsf-giannopoulos-3Vnv.jpg)
11.10.2023
Hematoonkologia.pl
Prof. Krzysztof Giannopoulos: Co nowego w obszarze G-CSF? [VIDEO]
2.02.2022
prof. Agnieszka Wierzbowska
Leczenie inwazyjnych zakażeń grzybiczych | Prof. Agnieszka Wierzbowska
Sponsor zakładki


















